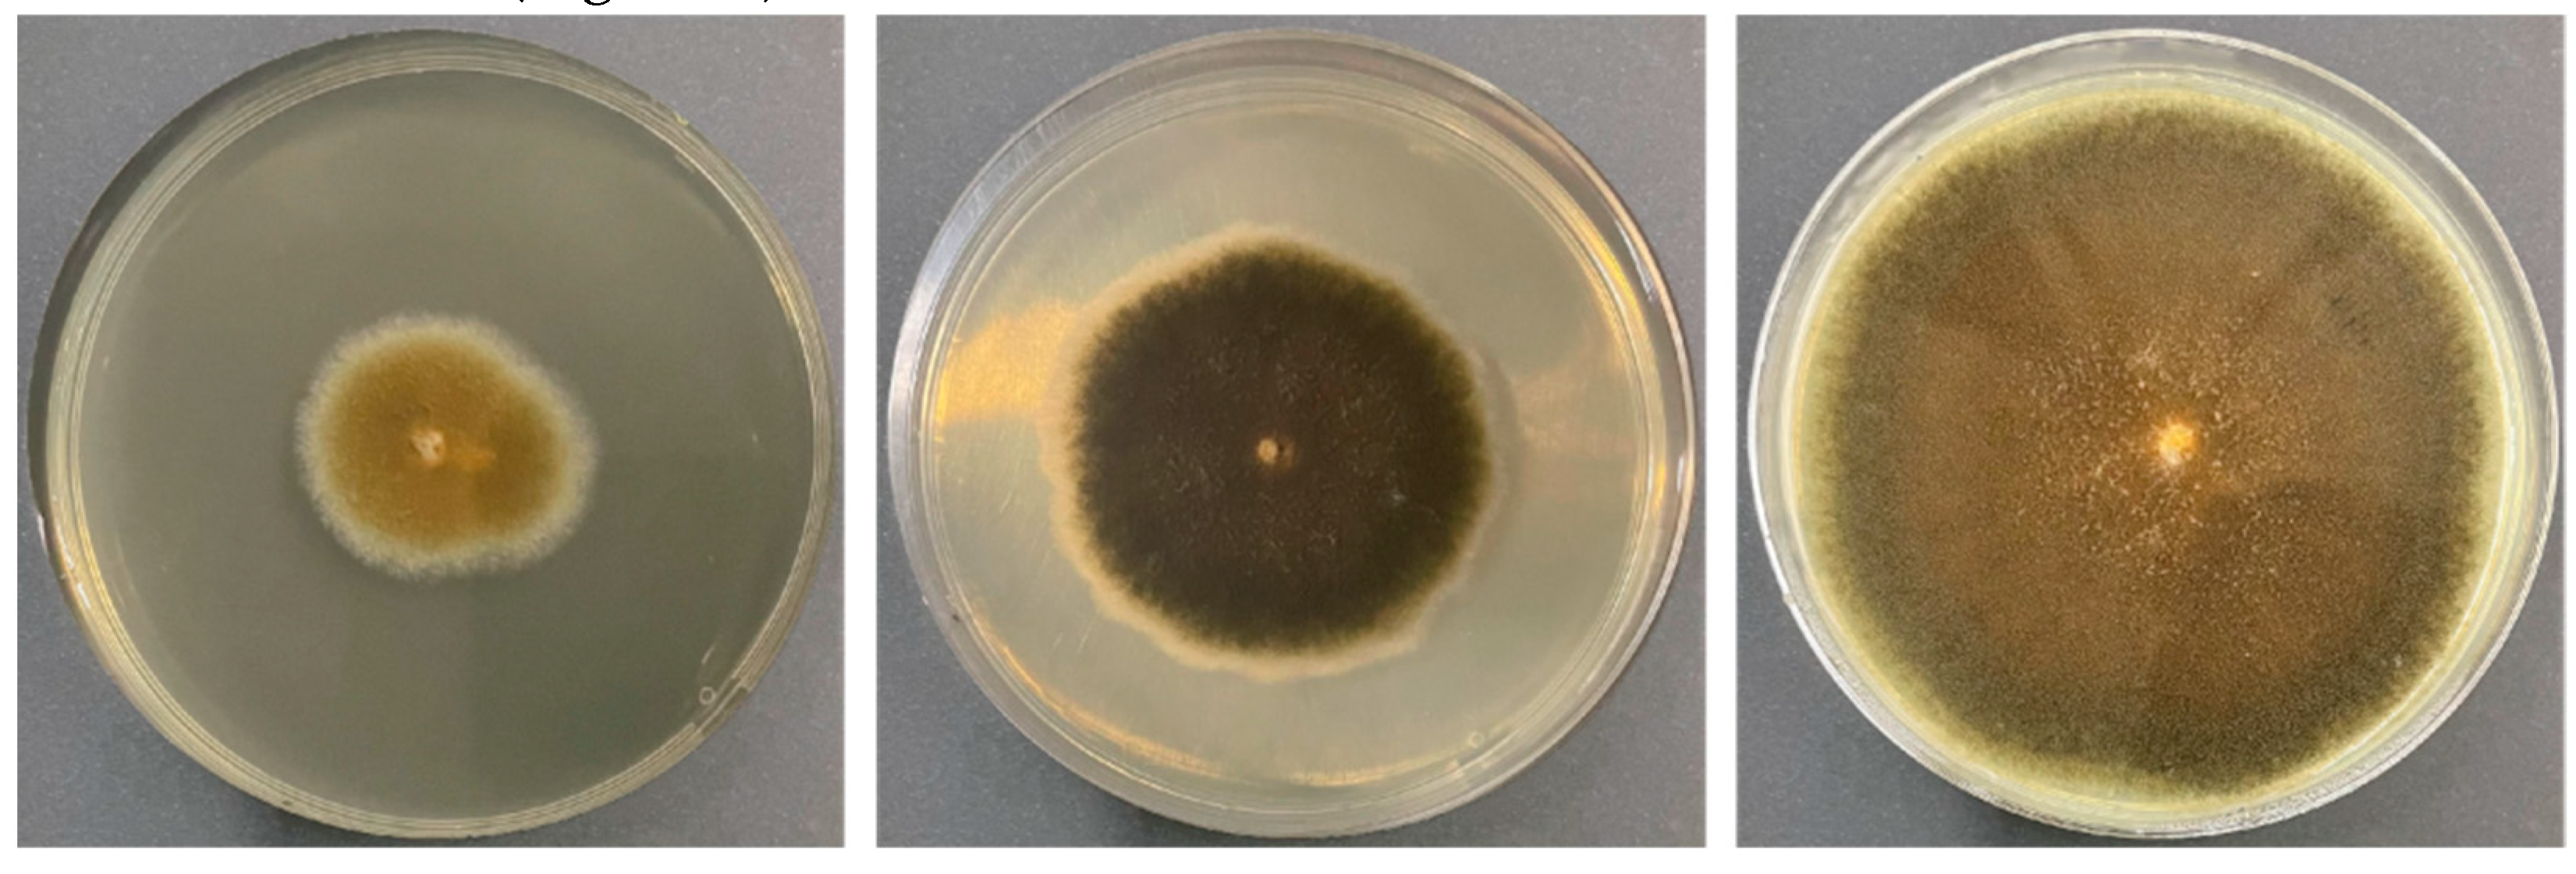
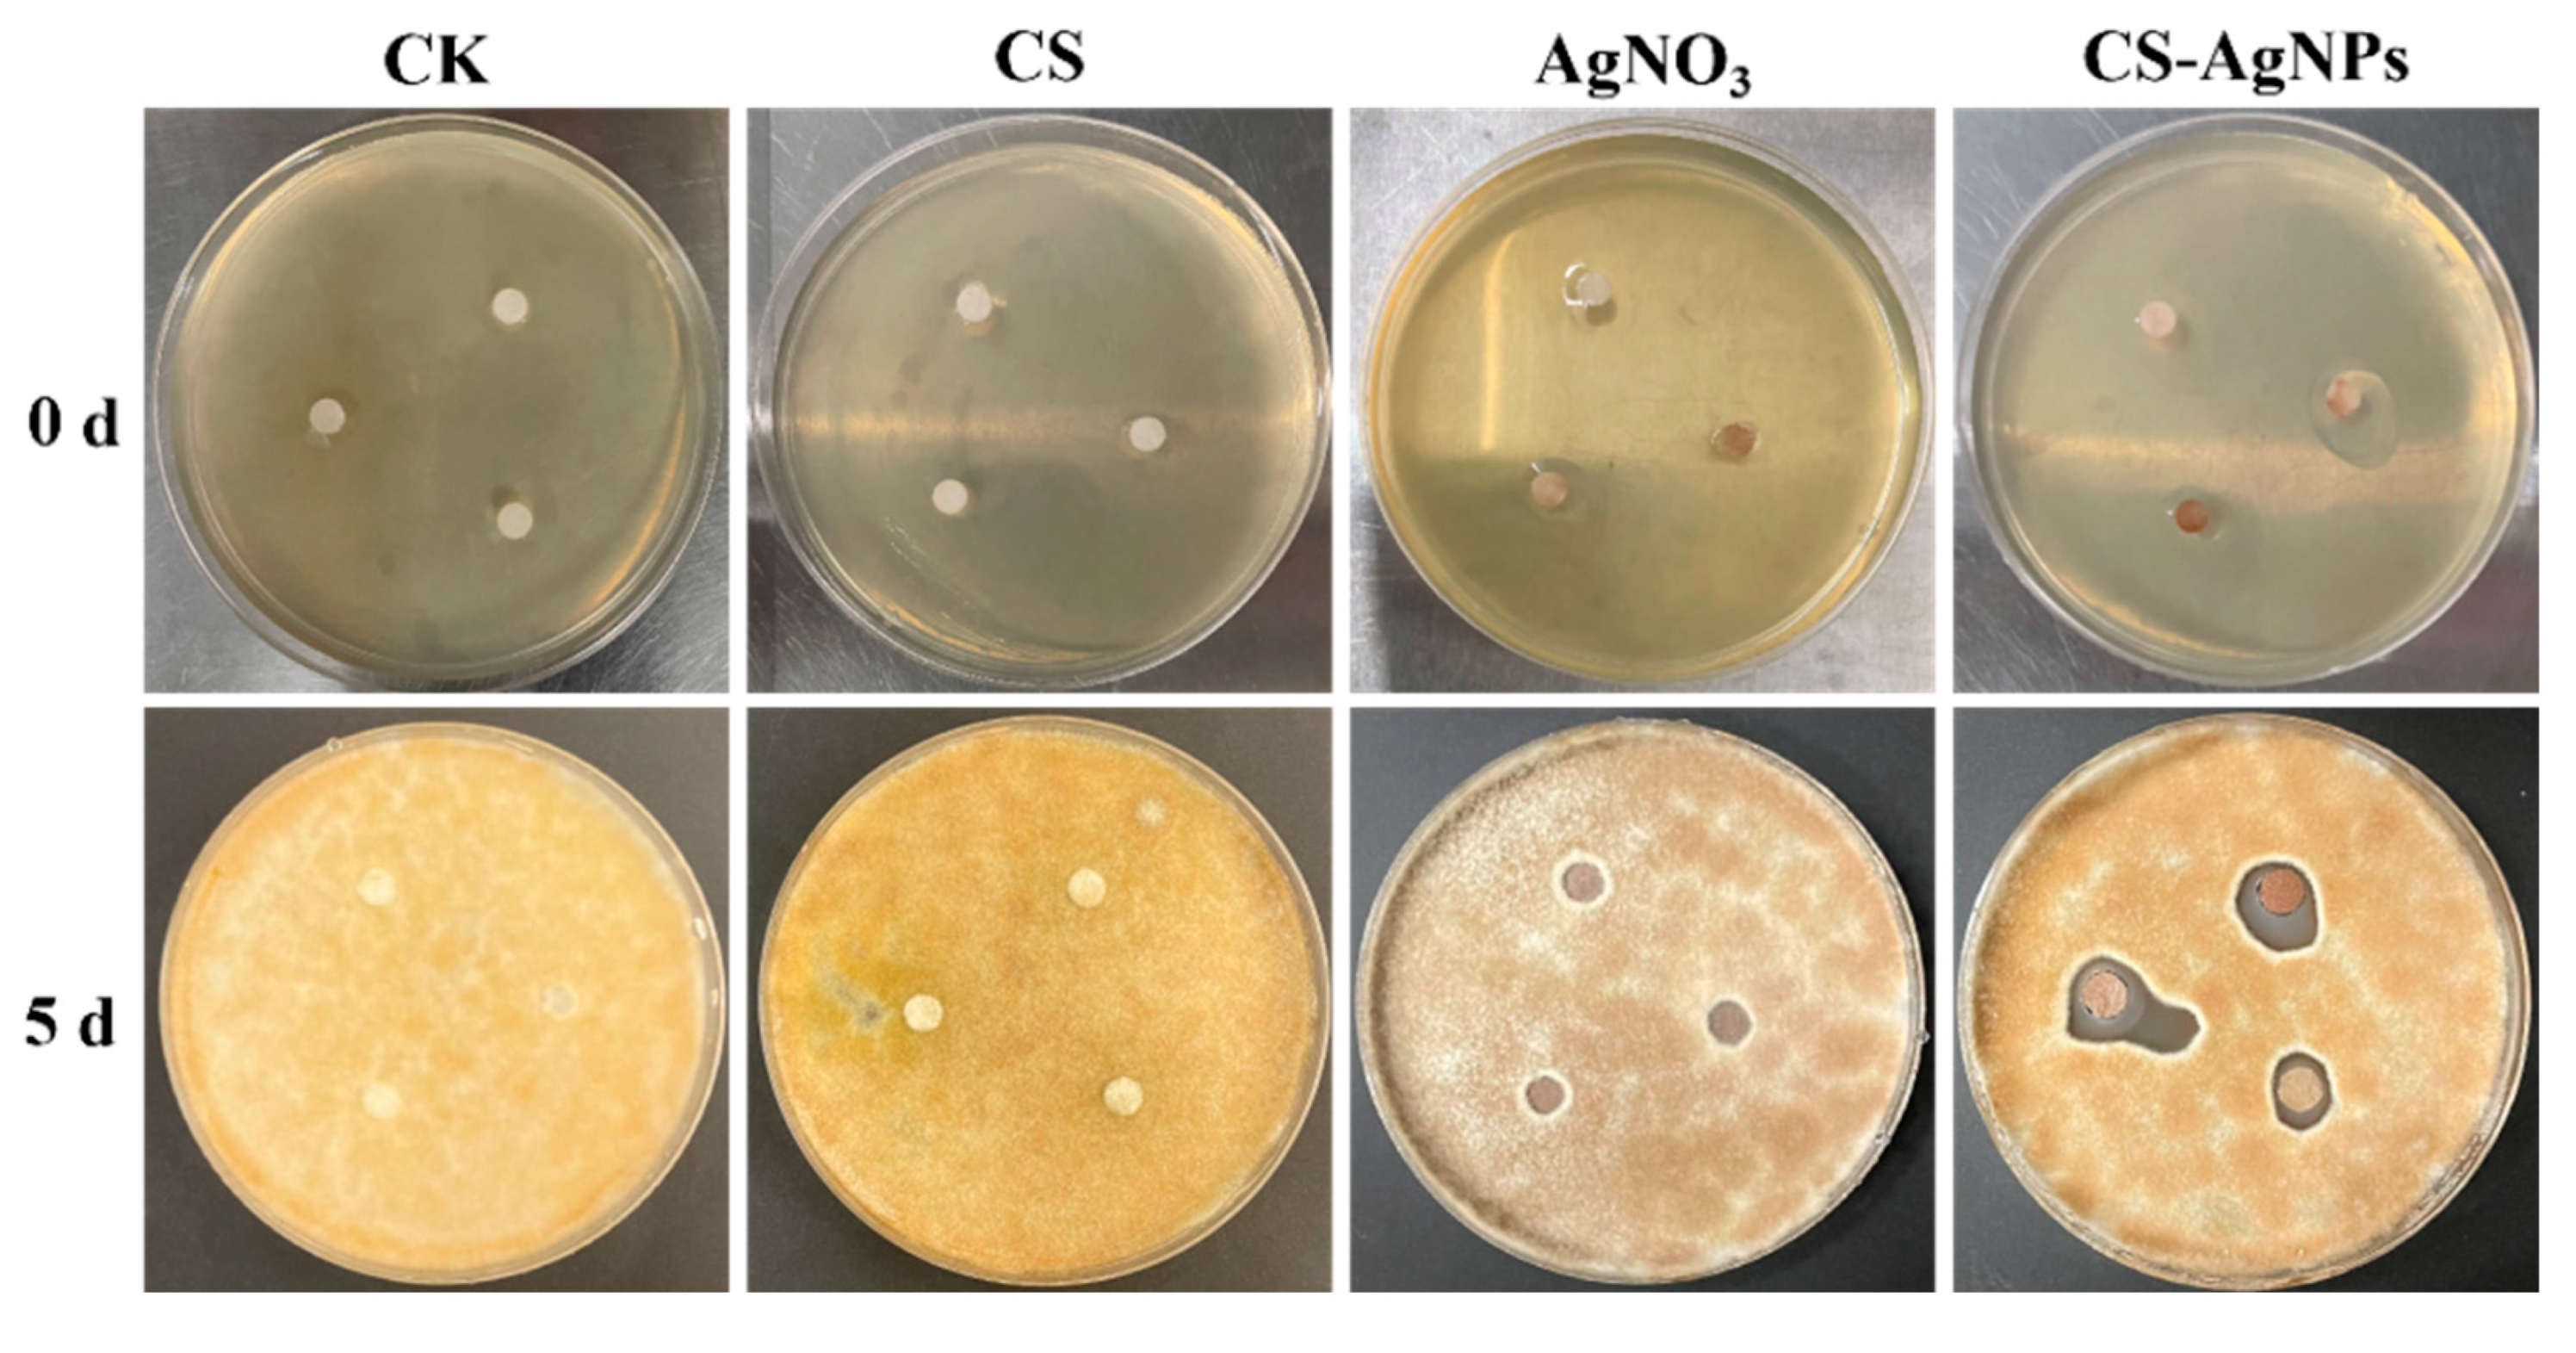

Submitted:
05 May 2024
Posted:
06 May 2024
You are already at the latest version
Abstract
Keywords:
1. Introduction
2. Results and Discussion
2.1. Fungal Identification
2.2. CS–AgNPs Hydrogel Characterization
2.3. Inhibition of CS-AgNPs Hydrogel on A. alternata In Vitro
2.4. Quantitative Assay of the Antimicrobial Activity
2.5. Residue of Silver in Jujube
3. Materials and Methods
3.1. Fruit Material and Chemical Material
3.2. Fungal Isolation, Identification, Culture and Spore Suspension
3.3. Characterization
3.4. Preparation of CS-AgNPs Hydrogel
3.5. Zone of Inhibition Test
3.5.1. Preparation of Fungal Suspension
3.5.2. Antibacterial Experimental Method
3.6. Quantitative Assay of the Antimicrobial Activity
3.6.1. The Minimal Inhibitory Concentrations (MIC) and the Minima Bactericidal Concentrations (MBC)
3.6.2. Fractional Inhibitory Concentration Index (FICI)
3.7. Residue of Silver in Jujube
4. Conclusions
Author Contributions
Funding
Data Availability Statement
Acknowledgments
Conflicts of Interest
References
- Solfrizzo, M. , Recent advances on Alternaria mycotoxins. Curr. Opin. Food Sci. 2017, 17, 57–61. [Google Scholar] [CrossRef]
- Chang, W.; Liu, F.; Sharif, H. R.; Huang, Z.; Goff, H. D.; Zhong, F. , Preparation of chitosan films by neutralization for improving their preservation effects on chilled meat. Food Hydrocolloid. 2019, 90, 50–61. [Google Scholar] [CrossRef]
- Zhao, J.; Wang, Y.; Li, J.; Lei, H.; Zhen, X.; Gou, D.; Liu, T. , Preparation of chitosan/Enoki mushroom foot polysaccharide composite cling film and its application in blueberry preservation. Int. J. Biol. Macromol. 2023, 246, 125567. [Google Scholar] [CrossRef] [PubMed]
- Liu, Y.; Liu, Q.; Li, X.; Hu, T.; Jatt, A.-N.; Zhang, C.; Gong, H. , Effects of postharvest chitosan and potassium sorbate coating on the storage quality and fungal community of fresh jujube. Postharvest Biol. Tec. 2023, 205, 112503. [Google Scholar] [CrossRef]
- Cheng, S.; Yu, Y.; Guo, J.; Chen, G.; Guo, M. , Effect of 1-methylcyclopropene and chitosan treatment on the storage quality of jujube fruit and its related enzyme activities. Sci. Hortic-amsterdam. 2020, 265, 109281. [Google Scholar] [CrossRef]
- Zhang, C.; Gong, H.; Liu, Y. , Effects of postharvest coating using chitosan combined with natamycin on physicochemical and microbial properties of sweet cherry during cold storage. Int. J. Biol. Macromol. 2022, 214, 1–9. [Google Scholar] [CrossRef]
- Dong, Z.; Li, R.; Gong, Y. , Antibacterial and Freshness-Preserving Mechanisms of Chitosan-Nano-TiO2-Nano-Ag Composite Materials. Coatings 2021, 11, 914. [Google Scholar] [CrossRef]
- García-García, D. J.; Pérez-Sánchez, G. F.; Hernández-Cocoletzi, H.; Sánchez-Arzubide, M. G.; Luna-Guevara, M. L.; Rubio-Rosas, E.; Krishnamoorthy, R.; Morán-Raya, C. , Chitosan Coatings Modified with Nanostructured ZnO for the Preservation of Strawberries. Polymers 2023, 15, 3772. [Google Scholar] [CrossRef] [PubMed]
- Mousazadeh, S.; Ehsani, A.; Moghaddas Kia, E.; Ghasempour, Z. , Zinc oxide nanoparticles and periodate oxidation in developing pH-sensitive packaging film based on modified gelatin. Food Packaging Shelf. 2021, 28, 100654. [Google Scholar] [CrossRef]
- Cheng, J.; Lin, X.; Wu, X.; Liu, Q.; Wan, S.; Zhang, Y. , Preparation of a multifunctional silver nanoparticles polylactic acid food packaging film using mango peel extract. International J. Biol. Macromol. 2021, 188, 678–688. [Google Scholar] [CrossRef]
- Kumar, S.; Shukla, A.; Baul, P. P.; Mitra, A.; Halder, D. , Biodegradable hybrid nanocomposites of chitosan/gelatin and silver nanoparticles for active food packaging applications. Food Packaging Shelf. 2018, 16, 178–184. [Google Scholar] [CrossRef]
- Zhang, Y.; Lin, Z.; He, Q.; Deng, Y.; Wei, F.; Xu, C.; Fu, L.; Lin, B. , Enhanced aqueous stability and long-acting antibacterial of silver-based MOFs via chitosan-crosslinked for fruit fresh-keeping. Appl. Surf. Sci. 2022, 571, 151351. [Google Scholar] [CrossRef]
- Saravanakumar, K.; Sathiyaseelan, A.; Mariadoss, A. V. A.; Xiaowen, H.; Wang, M.-H. , Physical and bioactivities of biopolymeric films incorporated with cellulose, sodium alginate and copper oxide nanoparticles for food packaging application. Int. J. Biol. Macromol. 2020, 153, 207–214. [Google Scholar] [CrossRef] [PubMed]
- Madian, N. G.; Mohamed, N. , Enhancement of the dynamic mechanical properties of chitosan thin films by crosslinking with greenly synthesized silver nanoparticles. J. Mater. Res. Technol. 2020, 9, 12970–12975. [Google Scholar] [CrossRef]
- Huynh, M. D.; Linh, N. T. D.; Chinh, N. T.; Trang, N. T. T.; Manh, V. Q.; Linh, N. N.; Thang, D. X.; Anh, N. T. L.; Nam, N. T.; Giang, N. V.; Trung, V. Q. , Preparation of preservative coating for tomatoes based on polyphenol modified chitosan and silver nanoparticles. Vietnam J. Chem. 2022, 60, 86–95. [Google Scholar] [CrossRef]
- Mouzahim, M. E.; Eddarai, E. M.; Eladaoui, S.; Guenbour, A.; Bellaouchou, A.; Zarrouk, A.; Boussen, R. , Effect of Kaolin clay and Ficus carica mediated silver nanoparticles on chitosan food packaging film for fresh apple slice preservation. Food Chem. 2023, 410, 135470. [Google Scholar] [CrossRef] [PubMed]
- Dananjaya, S. H. S.; Kulatunga, D. C. M.; Godahewa, G. I.; Lee, J.; De Zoysa, M. , Comparative study of preparation, characterization and anticandidal activities of a chitosan silver nanocomposite (CAgNC) compared with low molecular weight chitosan (LMW-chitosan). RSC Advances 2016, 6, 33455–33461. [Google Scholar] [CrossRef]
- Ji, M.; Li, J.; Li, F.; Wang, X.; Man, J.; Li, J.; Zhang, C.; Peng, S. , A biodegradable chitosan-based composite film reinforced by ramie fibre and lignin for food packaging. Carbohyd. Polym. 2022, 281, 119078. [Google Scholar] [CrossRef]
- Das, B.; Dash, S. K.; Mandal, D.; Ghosh, T.; Chattopadhyay, S.; Tripathy, S.; Das, S.; Dey, S. K.; Das, D.; Roy, S. , Green synthesized silver nanoparticles destroy multidrug resistant bacteria via reactive oxygen species mediated membrane damage. Arab. J. Chem. 2017, 10, 862–876. [Google Scholar] [CrossRef]
- Zhou, P.; Xia, Z.; Qi, C.; He, M.; Yu, T.; Shi, L. , Construction of chitosan/Ag nanocomposite sponges and their properties. Int. J. Biol. Macromol. 2021, 192, 272–277. [Google Scholar] [CrossRef]
- Zhang, Z.; He, T.; Yuan, M.; Shen, R.; Deng, L.; Yi, L.; Sun, Z.; Zhang, Y. , The in situ synthesis of Ag/amino acid biopolymer hydrogels as mouldable wound dressings. Chem. Commun. 2015, 51, 15862–15865. [Google Scholar] [CrossRef] [PubMed]
- Sun, Z.; Lv, F.; Cao, L.; Liu, L.; Zhang, Y.; Lu, Z. , Multistimuli-Responsive, Moldable Supramolecular Hydrogels Cross-Linked by Ultrafast Complexation of Metal Ions and Biopolymers. Angew. Chem. Int. Ed. 2015, 54, 7944–7948. [Google Scholar] [CrossRef] [PubMed]
- He, W.; Zhu, Y.; Chen, Y.; Shen, Q.; Hua, Z.; Wang, X.; Xue, P. , Inhibitory Effect and Mechanism of Chitosan–Ag Complex Hydrogel on Fungal Disease in Grape. Molecules 2022, 27, 1688. [Google Scholar] [CrossRef] [PubMed]
- Balouiri, M.; Sadiki, M.; Ibnsouda, S. K. , Methods for in vitro evaluating antimicrobial activity: A review. J. Pharm. Anal. 2016, 6, 71–79. [Google Scholar] [CrossRef]

| Sample | MIC (ppm) | MBC (ppm) |
|---|---|---|
| CS | 125 | 271 |
| AgNO3 | 7.8 | 31.2 |
| CS-AgNPs 1:3 | 3.8 | / |
| CS-AgNPs 1:2 | 4.2 | / |
| CS-AgNPs 1:1 | 5.4 | / |
| CS-AgNPs 2:1 | 6.8 | / |
| CS-AgNPs 3:1 | 7.1 | / |
Disclaimer/Publisher’s Note: The statements, opinions and data contained in all publications are solely those of the individual author(s) and contributor(s) and not of MDPI and/or the editor(s). MDPI and/or the editor(s) disclaim responsibility for any injury to people or property resulting from any ideas, methods, instructions or products referred to in the content. |
© 2024 by the authors. Licensee MDPI, Basel, Switzerland. This article is an open access article distributed under the terms and conditions of the Creative Commons Attribution (CC BY) license (http://creativecommons.org/licenses/by/4.0/).